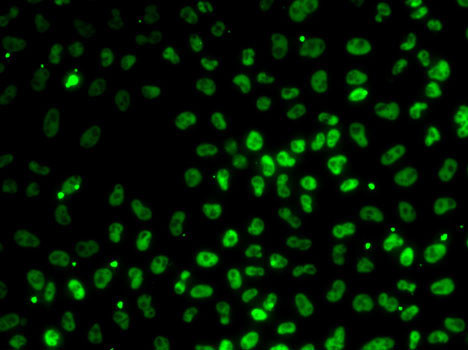
PPP1R8 Antibody in Immunocytochemistry (ICC/IF)

Search
Invitrogen
PPP1R8 Polyclonal Antibody
{{$productOrderCtrl.translations['antibody.pdp.commerceCard.promotion.promotions']}}
{{$productOrderCtrl.translations['antibody.pdp.commerceCard.promotion.viewpromo']}}
{{$productOrderCtrl.translations['antibody.pdp.commerceCard.promotion.promocode']}}: {{promo.promoCode}} {{promo.promoTitle}} {{promo.promoDescription}}. {{$productOrderCtrl.translations['antibody.pdp.commerceCard.promotion.learnmore']}}





Please note: We are reviewing Western blot images included in the antibody testing data in our catalog, including those provided by third parties. Unless expressly labeled or annotated as “raw-unedited”, Western blot images included in the antibody testing data in our catalog may have been edited, optimized or otherwise adjusted for presentation.
产品信息
PA5-121027
种属反应
宿主/亚型
分类
类型
抗原
偶联物
形式
浓度
规格
纯化类型
保存液
内含物
保存条件
运输条件
RRID
产品详细信息
Positive test controls include: HL-60, PC-12, HeLa, HepG2, 293T, Mouse brain. The target is usually found in the following locations: Cytoplasm, Nucleus, Nucleus speckle.
Immunogen sequence: MGGEDDELKG LLGLPEEETE LDNLTEFNTA HNKRISTLTI EEGNLDIQRP KRKRKNSRVT FSEDDEIINP EDVDPSVGRF RNMVQTAVVP VKKKRVEGPG SLGLEESGSR RMQNFAFSGG LYGGLPPTHS EAGSQPHGIH GTALIGGLPM PYPNLAPDVD LTPVVPSAVN MNPAPNPAVY NPEAVNEPKK KKYAKEAWPG KKPTPSLLI
靶标信息
This gene, through alternative splicing, encodes three different isoforms. Two of the protein isoforms encoded by this gene are specific inhibitors of type 1 serine/threonine protein phosphatases and can bind but not cleave RNA. The third protein isoform lacks the phosphatase inhibitory function but is a single-strand endoribonuclease comparable to RNase E of E. coli. This isoform requires magnesium for its function and cleaves specific sites in A+U-rich regions of RNA.
仅用于科研。不用于诊断过程。未经明确授权不得转售。
篇参考文献 (0)
生物信息学
蛋白别名: NIPP-1; Nuclear inhibitor of protein phosphatase 1; Protein phosphatase 1 regulatory inhibitor subunit 8; protein phosphatase 1, regulatory (inhibitor) subunit 8
基因别名: 6330548N22Rik; ARD1; AU044684; NIPP1; PPP1R8
UniProt ID: (Mouse) Q8R3G1
Entrez Gene ID: (Rat) 313030, (Mouse) 100336